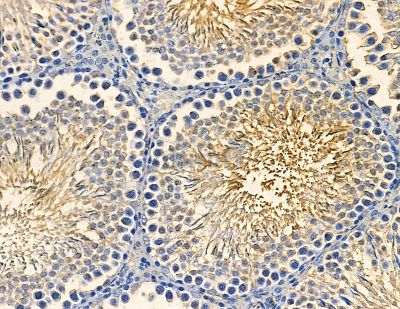
RICH2 Antibody - DF13841 at 1/100 staining rat testis tissue by IHC-P.

RICH2 Antibody - #DF13841
Related Downloads
Protocols
Product Info
*The optimal dilutions should be determined by the end user. For optimal experimental results, antibody reuse is not recommended.
*Tips:
WB: For western blot detection of denatured protein samples. IHC: For immunohistochemical detection of paraffin sections (IHC-p) or frozen sections (IHC-f) of tissue samples. IF/ICC: For immunofluorescence detection of cell samples. ELISA(peptide): For ELISA detection of antigenic peptide.
Fold/Unfold
KIAA0672; NPC A 10; Rho GTPase activating protein RICH2; Rho type GTPase activating protein RICH2; RhoGAP interacting with CIP4 homologs protein 2;
Immunogens
A synthesized peptide derived from Human RICH2.
- Q17R89 RHG44_HUMAN:
- Protein BLAST With
- NCBI/
- ExPASy/
- Uniprot
MKKQFNRMRQLANQTVGRAEKTEVLSEDLLQVEKRLELVKQVSHSTHKKLTACLQGQQGAEADKRSKKLPLTTLAQCLMEGSAILGDDTLLGKMLKLCGETEDKLAQELIHFELQVERDVIEPLFLLAEVEIPNIQKQRKHLAKLVLDMDSSRTRWQQTSKSSGLSSSLQPAGAKADALREEMEEAANRVEICRDQLSADMYSFVAKEIDYANYFQTLIEVQAEYHRKSLTLLQAVLPQIKAQQEAWVEKPSFGKPLEEHLTISGREIAFPIEACVTMLLECGMQEEGLFRVAPSASKLKKLKAALDCCVVDVQEYSADPHAIAGALKSYLRELPEPLMTFELYDEWIQASNVQEQDKKLQALWNACEKLPKANHNNIRYLIKFLSKLSEYQDVNKMTPSNMAIVLGPNLLWPQAEGNITEMMTTVSLQIVGIIEPIIQHADWFFPGEIEFNITGNYGSPVHVNHNANYSSMPSPDMDPADRRQPEQARRPLSVATDNMMLEFYKKDGLRKIQSMGVRVMDTNWVARRGSSAGRKVSCAPPSMQPPAPPAELAAPLPSPLPEQPLDSPAAPALSPSGLGLQPGPERTSTTKSKELSPGSAQKGSPGSSQGTACAGTQPGAQPGAQPGASPSPSQPPADQSPHTLRKVSKKLAPIPPKVPFGQPGAMADQSAGQPSPVSLSPTPPSTPSPYGLSYPQGYSLASGQLSPAAAPPLASPSVFTSTLSKSRPTPKPRQRPTLPPPQPPTVNLSASSPQSTEAPMLDGMSPGESMSTDLVHFDIPSIHIELGSTLRLSPLEHMRRHSVTDKRDSEEESESTAL
Research Backgrounds
GTPase-activating protein (GAP) that stimulates the GTPase activity of Rho-type GTPases. Thereby, controls Rho-type GTPases cycling between their active GTP-bound and inactive GDP-bound states. Acts as a GAP at least for CDC42 and RAC1. In neurons, is involved in dendritic spine formation and synaptic plasticity in a specific RAC1-GAP activity (By similarity). Limits the initiation of exploratory dendritic filopodia. Recruited to actin-patches that seed filopodia, binds specifically to plasma membrane sections that are deformed inward by acto-myosin mediated contractile forces. Acts through GAP activity on RAC1 to reduce actin polymerization necessary for filopodia formation (By similarity). In association with SHANK3, promotes GRIA1 exocytosis from recycling endosomes and spine morphological changes associated to long-term potentiation (By similarity).
Cell projection>Dendritic spine. Recycling endosome. Cell junction>Synapse>Presynapse. Cell projection>Dendrite.
Note: In CA1 hippocampal synapses, detected at both presynaptic and postsynaptic sites (By similarity). Located in convoluted dendritic plasma membrane sections enriched in polymerized actin and myosin (patches) along dendrites where often emerge filopodia (By similarity).
Highly expressed in brain. Expressed at weak level in other tissues.
Rho-GAP domain is required to promote GRIA1 exocytosis from recycling endosomes. Rho-GAP and BAR domains are necessary for the control of long-term potentiation in hippocampal neurons (By similarity). In dendrites, BAR domain mediates the recruitment to patches where plasma membrane is deformed by acto-myosin mediated contractile forces (By similarity).
Restrictive clause
Affinity Biosciences tests all products strictly. Citations are provided as a resource for additional applications that have not been validated by Affinity Biosciences. Please choose the appropriate format for each application and consult Materials and Methods sections for additional details about the use of any product in these publications.
For Research Use Only.
Not for use in diagnostic or therapeutic procedures. Not for resale. Not for distribution without written consent. Affinity Biosciences will not be held responsible for patent infringement or other violations that may occur with the use of our products. Affinity Biosciences, Affinity Biosciences Logo and all other trademarks are the property of Affinity Biosciences LTD.